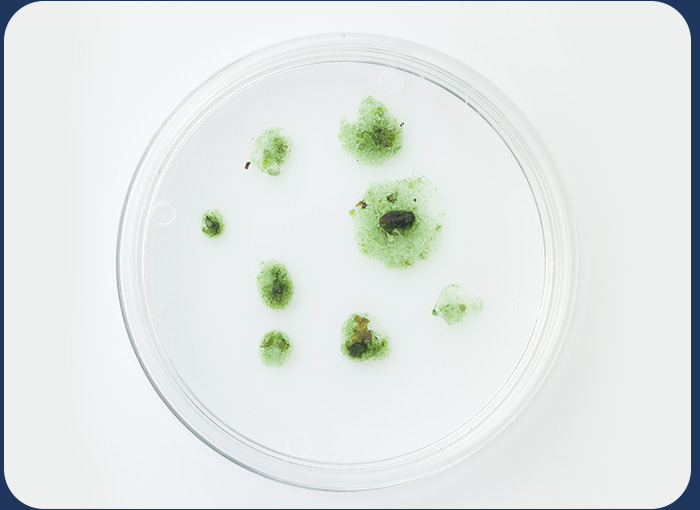
mold

Ozonguard Laundry 500
REASONS TO TRUST OZONE GUARD
OzoneGuard is a system that ozonizes the water and manages to eliminate 99.6% of germs and bacteria and we can use it both for the laundry and to clean any surface of the home without adding any chemical.
He the triple connection with the top push button allows us to have active water at any time to achieve a complete cleaning and sanitization of the home, achieving total disinfection of our home, without the need for detergents, bleaches, or any chemical product.

SPECIAL FEATURES
-
Elegant design
-
Smart Display with a built-in computer.
-
Includes special tap with pushbutton
-
Eliminates bacteria
-
Two levels of ozone
-
Automatic Air dryer
-
Double way cleaning: Washing machine and home hygiene
-
Easy to use
-
Clean and soft clothing
-
Disinfect Fruits and vegitable
-
Built-in prefiltration system remove havy sediment and chlorine from incoming water
-
Protect from allergy and SKIN IRRITATIONS


WHAT IS OZONE?
HOW IS IT PRODUCED?
It is produced naturally. It is a gas present in nature that is formed from three oxygen atoms. It is also possible to create ozone thanks to ozone generators, as an integrated equipment within the generator itself that captures oxygen from outside.
OXIDIZING ACTIONS OF OZONE
Thanks to its high oxidizing power, it is more powerful than chlorine. Ozone guarantees the destruction of biological microorganisms such as bacteria, viruses, fungi or spores, among others.
ADVANTAGES OF OZONE
Disinfectant power greater than chlorine and without residual flavor.
- Disinfection between 600 and 3000 times faster than chlorine.
- Leaves no chemical residue.
- Eliminates all bacteria.
- It is a natural gas.
USES OF OZONE
This is a faster and more effective application as a water disinfectant. Some of the applications of ozonized water are oral cleaning, disinfection of food and kitchen utensils, washing and disinfection of clothes, among others.
WHY INSTALL OZONEGUARD
Ozone is undoubtedly a future solution to the incipient needs of disinfection and safety, being at the forefront of technology, which enables an increasingly profitable
and effective production.

SOFTER, CLEANER CLOTHES THAN DETERGENT ALONE.
Testing shows that ozone (O3) infused into the water by Ozonguard 500, gently leaves clothes cleaner, softer and fluffier without using so much toxic laundry detergent and fabric softeners.

SAVES MONEY WITH EVERY WASH.
Save hundreds of dollars per year and significantly reduce energy costs by switching to this cold water solution. Not to mention cost savings from less detergent usage.

MIX YOUR LIGHT & DARK CLOTHES.
There’s no need for separate loads thanks to the patented, ozonation water process. It’s equally effective with all colors mixed together. Yes, it’s really that simple.
ELIMINATES BACTERIA AND MOLD.
Detergent build-up promotes mold growth and does not kill bacteria. Independent, scientific studies have proven Laundry 500 kills 99.9% of both with cold water.

90% – LESS DETERGENT.
With Laundry 500, you don’t need all that detergent to clean your clothes effectively. The power of natural ozonation eliminates dirt, bacteria, and mold better than detergent. Clean the way nature intended.

FEWER SKIN IRRITATIONS
Ideal for those who suffer from allergies triggered by bacteria and mold found living in our laundry. In addition, traditional laundry detergents are harsh on sensitive skins suffering from eczema, allergies, and other skin conditions. Pediatricians and dermatologists have recommended Laundry 500 to their patients to relieve detergent-related skin sensitivities, rashes, and other health issues.

LOVE YOUR ENVIRONMENT.
Eliminate hot water energy waste and chemicals that pollute the environment. Laundry 500 works with cold water and little to no detergent at all.

WASHING FRUITS AND VEGETABLES
Ozone will remove viruses and bacteria from fresh fruit and vegetables. The use of ozonated water to wash your fresh fruits and vegetables can produce a reduction of more than 99.99% in such food-borne microorganisms as salmonella, E.coli, Campylobacter, and many others.
HOW DIRTY IS YOUR WASHING MACHINE REALLY?
After running Laundry 500 through this washer, you can see how it instantly broke down the buildup. Over-usage of laundry products is the biggest problem for your machine. Too much soap shortens the lifespan of your washer. Laundry 500 will extend the life of your washer while cleaning your clothes better.



BUILT-IN AUTOMATIC HEATING AIR DRYER
Built-in automatic heating Air dryer is a unique feature of this system that removes moisture and protects the ozone generator(NO NEED REPLACE FILTERS every 2-3 months!!!)




















